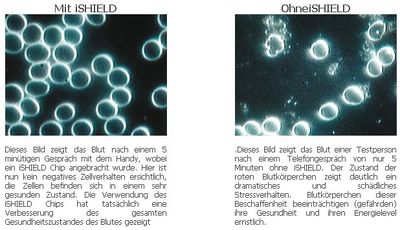

Shuzi

Shuzi ist der Handelsname für so genannte Elektrosmog-Schutzprodukte, die gleichzeitig als Schmuck ausgeführt sind. Shuzi-Produkte werden international vermarktet, so auch im deutschsprachigen Raum. Der Hersteller der Produkte wird in keiner Werbung genannt, dürfte aber entweder aus Neuseeland[2] oder Kalifornien stammen[3]
Zur Glaubhaftmachung werden wertlose "Gutachten" sowie anekdotische Jubelberichte angeblicher Kunden im Internet präsentiert. Hinzu kommen szenetypische Nennungen bekannter Sportler, die angeblich von den Shuzi-Produkten begeistert seien.
Shuzi - Produkte
Die Shuzi-Produkte mit Shuzi-Logo umfassen Fingerringe, Anhänger, Halsketten, Armbanduhren und auch einen "Schutz-Chip" namens "iShield". Als Material für den Schmuck wird Edelstahl angegeben. Der iShield-Chip soll (wie viele andere Produkten dieser Art) auf Mobiltelefone, PCs oder andere Geräte geklebt werden. Der simple Chipaufkleber soll "biologisch schädliche und gefährliche Erscheinungen der Mobiltelefoniestrahlung" reprogrammieren und in eine andere "Wellenform" verwandeln können, die unschädlich sei.
Angeblicher Funktionsmechanismus
Nach Angaben aus der Werbung sollen die Shuzi-Produkte mit einer "sehr feinen Energietechnologie", genannt "Nano Vibrations Technologie" (NVT) funktionieren. Dabei sollen "feine Vibrationen im Nanobereich" zum Einsatz kommen, um eine stärkere Frequenz für ein "Biofeld" und Zellen zu erschaffen, die es dem Körper ermöglichen, mehr Widerstand gegen die Auswirkungen von jeglichem Stress auszuüben, dem er ausgesetzt ist. Jedes Produkt soll über einen so genannten NVT-Chip aus einem "nicht magnetischen" Material verfügen. Das nicht genannte Material (offenbar ist hier Edelstahl gemeint) soll zusätzlich eine geheimnisvolle Filmschicht (Schichtfilm) aufweisen, die "programmiert" sei. Zu der "Programmierung" werden in der Produktwerbung Angaben mit pseudowissenschaftlichen Formulierungen gemacht. So wird eine "Programmierung" auf Grundlage einer ansonsten nicht näher erläuterten "ELECTRO MIGRATION (Elektronenwanderung)" und einer "Skalarinduktion" behauptet. Nach der "Programmierung" entstehen im Produkt angeblich "multiple identische Sender", die eine nicht genannte "Frequenz" ausstrahlen sollen. Der NVT-Chip sei so programmiert, dass er viele einzelne Frequenzen abgebe. Alle "Sender" zusammen sollen eine "subtile Vibrationsenergie" erzeugen, die mit einem nicht näher erläuterten "menschlichen Biofeld" interagiere, wenn sich dieses innerhalb von 8 cm zum Produkt befinde. Die Folge seien positive Auswirkungen bei Schlafstörungen, Gelenkschmerzen oder Allergien.
Zitat aus der Werbung:
- Zellen müssen optimal miteinander kommunizieren um sich wohl zu fühlen. Alle Produkte von Shuzi Austria helfen dabei, die Kommunikation zu stärken. Mit Hilfe unserer Produkte werden Sie erfahren, wozu Ihr Körper ganz alleine und ohne Zusätze im Stande ist. Egal ob Sie an Schlafstörungen, Gelenksschmerzen, Allergien u.ä. leiden, wir können Ihnen helfen.
Bei Amazon wird ein Shuzi-Produkt so beworben:
- Dieses aussergewöhliche Armband ist eigentlich viel mehr - es ist ein "NVT-Technologie Harmonisierer, es aktiviert und stärkt das menschliche Biofeld, so dass Ihr Körper und Geist widerstandsfähiger gegen die Auswirkungen von Stress in jeglicher Form wird. Es ist ihr persönliches Energie-System, bringen Sie Ihr ganzes Wesen in einen Zustand der Balance; es hilft Ihrem Körper stärker zu sein, Ihre Gedanken sind klarer und Ihre Ausdauer wird sich merklich erhöhen. Einfach gesagt, Shuzi hilft einfach, dass Sie sich besser fühlen und harmonisiert Körper und Geist, so können Sie ihr bestes geben - egal was Sie tun wollen! ... Alle Produkte von Shuzi Germany helfen dabei, die Kommunikation zu stärken. Mit Hilfe unserer Produkte werden Sie erfahren, wozu Ihr Körper ganz alleine und ohne Zusätze im Stande ist. Egal ob Sie an Schlafstörungen, Gelenkschmerzen, Allergien u.ä. leiden, wir können Ihnen helfen. SHUZI stärkt Ihr Biofeld auf natürliche Art und Weise! Ihr Körper kann sich schneller und einfacher auf Neues einstellen und selbst regulieren. Sie werden erhöhte Energie und Stärke bemerken, größere Ausdauer und Flexibilität, bessere Balance und geistige Konzentration.[4]
"Gutachten"
In der Werbung zu Shuzi werden verschiedene Auftrags-"Gutachten" genannt, die - wie zu erwarten - stets positive Ergebnisse liefern.
Die "Shuzi-Austria" beauftragte eine Firma "Delta Scan", um ihr Produkt "iShield" (zum Schutz gegen gefährliche Handystrahlen) begutachten zu lassen. Delta-Scan ist der Name eines pseudomedizinischen Produkts, das auch unter dem Namen Metascan bekannt ist. Der beauftragte "Energetiker" Markus Buchhauser aus dem österreichischen Köflach vertreibt nicht nur die Delta-Scan-Geräte, sondern auch Shuzi-Produkte, wie er selbst mitteilt.[5]
Des Weiteren sollen die Shuzi-Produkte mit Hilfe der Dunkelfeldmikroskopie ihre Wirksamkeit zeigen. Die Dunkelfeldmikroskopie ist jedoch kein anerkanntes Verfahren zur Messung elektromagnetischer Felder oder etwaiger gesundheitlicher Gefahren. Diese Methode wird häufig genannt, da fälschlich angenommen wird, dass es in Anwesenheit elektromagnetischer Felder zu einer so genannten Geldrollenbildung roter Blutkörperchen komme. Auch für diese Behauptung liegen keine wissenschaftlichen Belege vor.
Auch Bioresonanzgeräte wie "Bio Meridian MSA-21" oder Wärmebildkameras sind weder geeignet, elektromagnetische Felder nachzuweisen noch gesundheitsgefährende Einflüsse derartiger schwacher Felder anzuzeigen.
Anbieter
Im deutschsprachigen Raum werden die Shuzi-Produkte einerseits in Deutschland von einer "Shuzi Germany" und "Golf Versand Limited"[6] und andererseits von einer "Shuzi Austria"[7] vermarktet. Der Inhaber der Shuzi-Austria, Karl Heinz Weinzerl, ist gleichzeitzig Inhaber der Firma TKSF Telekomservice, die erstaunlicherweise gleichzeitig GSM-repeater, UMTS-repeater sowie weitere Produkte der drahtlosen GSM-Technik (Ortungssender) anbietet.
Ähnliche Produkte
Quellennachweise
- ↑ aus einer Ebay-Peoduktwerbung der Firma Golf Versand [1]
- ↑ SHUZI EVENTS LTD. 34, Miller st, Pt Chevilier, Auckland, NZ
- ↑ iHealthProducts, 1701 E. Edinger, Suite C-1, Santa Ana, CA 92705 - USA
- ↑ http://www.amazon.de/Shuzi-Armband-TITANIUM-BRLT004-Magnetschmuck/dp/B004EYHD12
- ↑ http://www.xing.com/profile/Markus_Buchhauser Zitat: Markus Buchhauser - Energetiker 8580 Köflach, Österreich. Ich biete DELTA-Scan Analyse und Vertrieb Österreich, sowie SHUZI Vertrieb. Ich suche Vertriebspartner SHUZI (Schmuck zum Wohlbefinden mit indegrierten Chip) in Deutschland
- ↑ Golf Versand Ltd., Ursula Axer, Schulstr. 21, D-40764 Langenfeld
- ↑ Shuzi Austria, Inh. Karl Heinz Weinzerl, Bucherlweg 59A, A - 8071 Grambach

